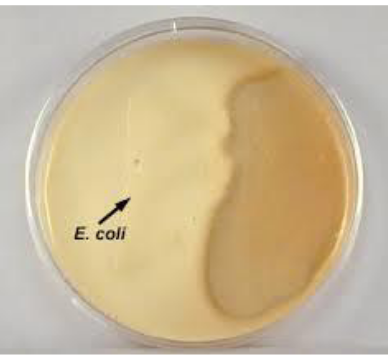
term image
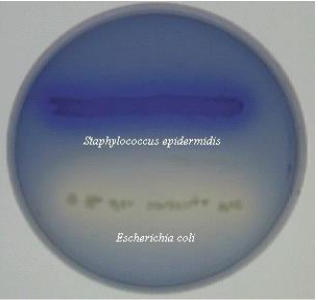
<p>lipid hydrolysis</p>
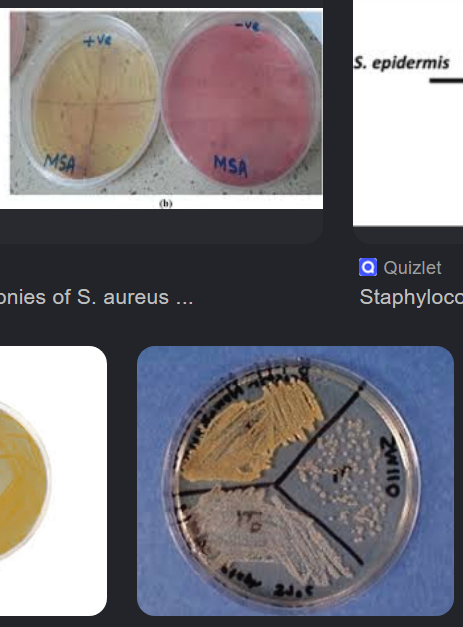
<p>MSA: selective due to high salt concentration; differential because s. aureus ferments mannitol making it yellow</p><p>SM110: selective due to high salt concentration; differential because s. aureus shows up golden due to a pigment <span>staphyloxanthin</span></p>

Physiological Tests etc.
1/18
There's no tags or description
Looks like no tags are added yet.
Name | Mastery | Learn | Test | Matching | Spaced | Call with Kai |
|---|
No analytics yet
Send a link to your students to track their progress
19 Terms

Methyl Red-Voges Proskauer (MR-VP)
fermentation test
red is positive

glucose fermentation test
fermentation test
yellow is positive

tryptophan degradation test
reagent: kovac’s reagent
positive is red
casein hydrolysis

citrate utilization test
fermentation test
blue is positive

oxidase test
oxidative test
reagent: oxidase reagent
aerobic cellular respiration!!!
purple is pos

starch hydrolysis
reagent: gram’s iodine

catalase test
oxidative test
reagent: hydrogen peroxide
bubbles pos

phenylalanine deamination test
ferric chloride reagent
blue is pos

urea hydrolysis
pink is pos
lipid hydrolysis
spirit blue agar
no reagents
dark blue pos

nitrate reduction test
oxidative test
reagents: nitrate reagent A, nitrate reagent B, zinc
pos is red after nitrate reagents A and B OR colorless after nitrate reagents A and B and zinc

SIM test
s = sulfide, I = indole, M = motility
pos for S is black
pos for indole is pink ring
pos for motility is cloudiness

kligler’s iron agar
all yellow = glucose and lactose fermentation
red slant = only glucose
all red = no fermentation
black = sulfide production, yellow butt under (because it needs an acidic enviorment)
b. subtils positive tests?
starch hydrolysis
caesin hydrolysis
e. coli positive tests?
tryptophan degradation
kligler’s iron agar (all yellow + gas production)
glucose fermentation
p. vulgaris positive tests?
kligler’s iron agar for hydrogen sulfide (and glucose fermentation)
SIM test (all)
urea hydrolysis
what are the two selective media for s. aureus? explain positive results. what makes these media selective?
MSA: selective due to high salt concentration; differential because s. aureus ferments mannitol making it yellow
SM110: selective due to high salt concentration; differential because s. aureus shows up golden due to a pigment staphyloxanthin